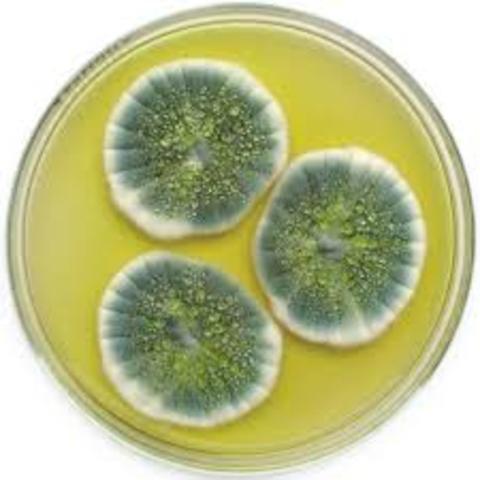
Interrupcion de la formacion del hongo

-
En oriente medio, el hombre aprendió a cultivar plantas, domesticar y cuidar animales.
-
El hombre descubre y maneja los metales
-
Los físicos rusos publicaron la obtención del elemento número 104 en cantidades muy pequeñas.
-
Woodward sintetizo un compuesto coplejo relacionado con la acromicina, un antibiotico muy conocido
-
Woodward sintetizo la Clorofila
-
Los quimicos aprendieron a interrumpir la formacion del hongo en su fase media y obtener el nucleo central de la malecula de penicilina
-
Woodward sintetizo la reserpina, el primer tranquilizante
-
Robert Burns sintetizo la estricnina
-
El químico Americano Vincent du Vigneaud rompiendo el hielo sintetizado oxitocina
-
El quimico ingles Frederick Sanger se centro en el estudio de la insulina
-
Watson constituye un importante avance en la comprension de la genetica
-
Burns sintetizo el colesterol y la cortisona
-
El quimico Americano Linus Pauling surgio que la cadena polipeptidica estaba arroyada en una estructura helicoidal (como una "escalera en espiral") que se mantenia en su sitio mediante enlaces de hidrogeno.
-
Robert Robinson descubrio la estricnina
-
Un proceso de cultivo de hongos y consentracion del producto rendia media tonelada de penicilina al mes
-
Se fabricaron ciertos dispositivos en los que al explotar una pequeña carga de explosivo se juntan dos trozos de uranio
-
Burns y su colega william von Egger sintetizaron la quinina
-
Laurence y Jonh Porterper perfeccionaron la tecnica, quienes utilizaron papel de filtro absorbente en lugar de la columna de polvo.
-
Se comprobó que el plutonio era fisionable
-
Un isótopo de carbono radiactivo poco común fue descubierto
-
Edwin McMillan en su trabajo sobre el bombardeo neutrónico del uranio, detectaron de hecho un nuevo tipo de átomo.
-
Hahn comenzó a preguntarse si no sería un isótopo radiactivo
-
Rudolf Schoenheimer realizó importantes investigaciones sobre grasas y proteínas utilizando hidrógeno-2 y nitrógeno-15.
-
El químico Alemán Gerhard Domagk descubrió que la sulfanilamida y algunos compuestos derivados podrían utilizarse para combatir diversas enfermedades infecciosas
-
fue detectado el anti-electron por Cari Anderson
-
El fisico ingles James Chadwick descubrio una particula que tenia exactamente la misma masa que el proton, pero no poseia ninguna carga electrica, se denomino neutron.
-
Ernest Lawrence diseñó un acelerador que obligaba a las partículas a moverse según una espiral que se ampliaba lentamente
-
El bacteriólogo escoces Alexander Fleming descubrió accidentalmente la penicilina
-
El ayudante de Suedberg, Arne Tiselius ideo una técnica para separar las moléculas gigantes en base a las distribuciones de carga eléctrica sobre la superficie molecular la cual llamo electroforesis
-
El químico ingles Robert Robinson descubrió la estructura de la morfina
-
Se descubrió el rhenium
-
Theodoro Suedberg desarrollo la ultra centrifuga
-
Se descubrió el hafnio
-
El químico danes Johannes Nicolaus introdujo un nuevo punto de vista acerca de los ácidos y las bases. Un ácido se definió como un compuesto que tenia a ceder un protón, mientras que una base era un compuesto que tenia a ceder un protón.
-
Rutherford demostró que las partículas alfa podían arrancar
protones de los núcleos de nitrógeno, y fusionarse con lo que quedaba. -
Los quimicos alemanes, Otto y Lise descubrieron el protactinio
-
El químico austriaco Fritz Pregl había ideado una eficaz técnica de micro análisis de sustancias
-
Moseley hallo que la longitud de onda disminuye lentamente a medida que aumentaba el peso atómico de los elementos que los emiten.
-
El bacteriólogo Alemán Paul Ehrlich utilizo la arsfenamina como agente terapéutico contra la Sifilis
-
Fue sintetizado un nuevo compuesto denominado sulfanilamida
-
Jean Perrin obtuvo la primera estimación segura del diámetro de las moléculas y de los átomos
-
Emil Fischer probo que la porción amino de un aminoácido se unía a la porción ácido de otro para formar un enlace peptídico
-
El botánico ruso Mijail Tsuett dejó gotear una mezcla de pigmentos vegetales coloreados, las diferentes sustancias se adherían al polvo. al lavar los componentes se separaban para formar bandas de color.
-
Fue Rutherford quien utilizó tales "cañones de partículas" con mas eficacia, comenzó bombardeando delgadas láminas de metal con partículas alfa rápidas.
-
Albert Einstein demostró que el movimiento browniano puede atribuirse al bombardeo de las partículas por moléculas de agua
-
Los gases nobles debían poseer una configuración electrónica especialmente rotable
-
El físico alemán Philipp Anton demostró que el efecto fotoeléctrico se producia por la emisión de electrones por parte de el metal.
-
La descripción de la estructura molecular en tres dimensiones fue universalmente aceptada
-
El físico alemán Ernist Dorn descubrió un gas radioactivo que posteriormente recibió el nombre de radón.
-
Crookes descubrió que los compuesto de uranio puro recién preparados eran sólo débilmente radiactivos, pero que su radiactividad se reforzaba con el tiempo.
-
El químico frances Andre Louis descubrió el Actinio
-
Curie trabajaba intensamente en grandes cantidades de mineral, tratando de concentrar la radioactividad y de aislar el nuevo elemento.
-
Ramsay supo que en Estados Unidos se habían obtenido muestras de un gas a través de un mineral de uranio y halló que no pertenecía ni al nitrógeno ni al argón
-
El físico alemán Wilhelm se hallaba interesado en la catadicos para provocar la luminiscencia de determinadas sustancias químicas. oscureció la habitación y envolvió su tubo de vacío en una cartulina negra, con dicho tubo observó un destello de luz que no provenía de este.
-
Ramsay repitió el experimento de Cavendish y aplico unos instrumentos analiticos que este no poseia
-
Ostwald publicó en su revista un resumen de un trabajo de otro autor sobre el calor
-
Werner desarrolló una teoría de la coordinación de la estructura molecular
-
Johann Adolf utilizó la representación tridimensional para dibujar átomos de carbono fijos a anillos planos
-
Carl Welsbach que el didimio era una mezcla de dos elementos las cuales llamo praseodimio y neodimio
-
Friedrich Beilstein publicó un resumen de compuestos orgánicos y utilizó la teoría de Laurent para organizar dichos compuestos dentro de un orden racional
-
El trabajo quizá más espectacular fue el de Emil Fischer sobre la química de los azúcares simples
-
Lars Nilsson descubre un nuevo elemento al que llamó escandio
-
Josiah Gibbs publicó las leyes de la termodinámica a las reacciones químicas
-
El botánico Alemán Wilhem Pfeffer demostró que se podía medir la presión osmótica
-
Jacobus Van't Hoff sugirió atrevidamente que los cuatro enlaces del carbono estaban distribuidos en las tres dimensiones del espacio hacia los cuatro vértices de un tetraedro
-
Johannes Diderik elaboró una ecuación que relacionaba la presión, el volumen y la temperatura de los gases
-
Se fijó de modo especial en tres huecos: los que quedaban junto a los elementos de boro, aluminio y silicio en la tabla, tal como se había modificado aquel año
-
Meyer publicó su trabajo sobre que el segundo y tercer periodo de la tabla comprendía siete elementos pero ya era demasiado tarde
-
Mendeleiev publicó su tabla un año antes de que Meyer publicará su trabajo
-
Un estudiante discípulo de Baeyer, sintetizo la alizarina, otro importante colorante natural
-
Baeyer comenzó un programa de investigación que posteriormente condujo a la síntesis del Índigo
-
Clemens Winkler encontró un nuevo elemento llamado germanio
-
Kekule pensó y sugirió la fórmula de anillos de carbono
-
Hofmann regresa a Alemania y allí lanza el nuevo campo de la química orgánica
-
John Newlands ordenó los elementos conocidos según sus pesos atómicos crecientes y observó que las propiedades tenían un orden al menos parcial
-
Cato Guldberg y Peter Waage publicaron un folleto que trataba del sentido de las reacciones espontáneas
-
Kekulé en un libro de texto definió la química orgánica simplemente como la química de los compuestos de carbono. La química inorgánica era entonces la química de los compuestos que no contenían carbono, definición que ha sido generalmente aceptada.
-
Jean Servais Stas determinó los pesos atómicos con más exactitud que Berzelius.
-
Alexander Butlerov señaló cómo el uso de las fórmulas
estructurales podía explicar la existencia de isómeros -
El primer congreso internacional de química se reunió en la ciudad de Karlsruhe, en Alemania
-
Bunsen y Kirchhoff examinaron un mineral con líneas espectrales desconocidas y probaron que era un metal alcalino
-
Kekule sugirió que el carbono tiene una valencia de cuatro y comenzó a elaborar la estructura de las moléculas orgánicas más simples
-
Perkin obtuvo lo que llamó "púrpura de anilina" lo que luego los tintoreros franceses denominaron el color del tinte "malva"
-
Berthelot calentó glicerol con ácido esteárico, uno de los ácidos grasos más comunes obtenidos de las grasas, y se encontró con una molécula formada por una unidad de glicerol unida a tres unidades de ácido esteárico, esta era la triestearina.
-
Johann Hittorf señaló que algunos iones viajaban más rápido que otros
-
Frankland propuso la teoría de valencia. La cual consiste en que cada átomo tiene un poder de combinación
-
Gustav Kirchhoff y Robert Bunsen dieron una cantidad de información sobre aquellas lineas de Joseph von Fraunhofer
-
Eugéne Marcelin efectuó sistemáticamente la síntesis de compuestos orgánicos, confeccionando unas tablas. Incluían sustancias tan conocidas e importantes como el alcohol metílico, alcohol etílico, metano, benceno y acetileno.
-
Alexander Williamson demostró que la familia de compuestos organicos tambien podia formarse según el tipo de agua
-
Clausius demostró que en cualquier cambio espontáneo de energía la entropía del sistema se incrementa
-
Berzelius murio junto con su teoria y la de Laurent gano popularidad
-
Charles Adolphe habia estudiado un grupo de compuestos relacionados con el amoniaco (aminas) y demostro que pertenecian a un tipo con nucleo de nitrogeno
-
Aparece el primer indicio de comprensión de la actividad óptica
-
Adolph Wilhelm sintetizó ácido acético, una sustancia indudablemente orgánica.
-
Mayer y Hermann Ludwig realizaron un trabajo el cual puso en claro que la energía no se crea, ni se destruye
-
Dumas sustituyó cloro en el lugar ocupado por tres átomos de hidrógeno en el ácido acético
-
André Dumas ideó un método que permitía al químico recoger también el nitrógeno entre los productos de combustión. De esta manera podían detectarse las proporciones de nitrógeno en una sustancia orgánica.
-
Faraday pudo proclamar la existencia de ciertas relaciones cuantitativas en electroquímica.
-
Thomas Graham logró demostrar que la velocidad de difusión de un gas inversamente proporcional a la raíz cuadrada de su peso molecular
-
Se conocían cincuenta y cinco elementos diferentes, un buen paso desde los cuatro elementos de la antigua teoría
-
Johann Wolfgang observó que el elemento bromo parecía tener propiedades que estaban justo a mitad de camino entre las del cloro y las del yodo
-
Berzelius publicó la primer tabla de pesos atómicos.
-
Liebig estudió un grupo de compuestos, los fulminatos, mientras Wóhlers estaba estudiando otro grupo de compuestos, los cianatos.
-
Henri Braconnot trato (de la misma manera que Sigismund convirtió el algodón) la gelatina y obtuvo el compuesto glicina que se trata de un ácido orgánico que contiene nitrógeno y pertenece a un grupo de sustancias que Berzelius llamó aminoácidos.
-
Eilhardt Mitscherlich descubrió que que los compuestos de composición semejante tienden a cristalizar juntos, como si las moléculas de uno se entremezclasen con las moléculas de
configuración semejante del otro. -
Pierre Louis Dulong y Alexis Thérése Petit descubrieron que el calor específico de los elementos, el aumento de temperatura que sigue a la absorción de una cantidad fija de calor parecía variar inversamente con el peso atómico.
-
Wiliam Prout planteo que todos los elementos estaban en definitiva compuestos de hidrógeno. Los diversos elementos tenían distintos pesos porque estaban compuestos de diferente
número de átomos de hidrógeno aglutinados. -
Las propiedades y el comportamiento de la luz polarizada pertenecian exclusivamente a la fisica
-
Joseph von Fraunhofer estaba experimentando los excelentes prismas que el mismo fabricaba y halló que la luz formaba un espectro de colores, cruzado por una serie de líneas
-
Augustin Fresnel mostró que las ondas de luz pertenecen a un tipo de ondas transversales
-
Gottlieb Sigismund logró convertir almidón (calentándolo con ácido) en un azúcar simple que llamó finalmente glucosa.
-
Gay-Lussac había obtenido las fórmulas empíricas de algunos azúcares simples.
-
Gay-Lussac y Thénard trabajaron con cianuro de hidrógeno, demostrando que era un ácido, aunque no contenía oxígeno.
-
Eugéne Chevreul trato jabón fabricado por calentamiento de grasa con álcali, con ácido, y aisló lo que ahora se llaman ácidos grasos.
-
Dalton publico un nuevo sistema de Filosofía Química, en el que discutían con gran detalles su teoría atómica.
-
Gay-Lussac llegó a averiguar, que cuando los gases se combinan entre sí para formar compuestos, siempre lo hacen en la proporción de números enteros pequeños.
-
Davy aisló varios metales de sus óxidos: magnesio de la magnesia, estroncio de la estroncianita, bario de la baritina y calcio de la cal.
-
Etienne Malus propuso que la luz que oscila en un solo plano se llama luz polarizada
-
Berzelius se lanzó a determinar la constitución elemental exacta de distintos compuestos. Mediante cientos de análisis, proporcionó tantos ejemplos de la ley de las proporciones definidas que el mundo de la química no podría dudar más de su validez y tuvo que aceptar.
-
Davy hizo pasar una corriente a través de potasa fundida (carbonato potásico) y liberó pequeños glóbulos de un metal que inmediatamente llamó potasio. Era tan activo que liberaba al oxígeno del agua desprendiendo hidrógeno con energía suficiente como para provocar su combustión con llama.
-
Berzelius planteo que las sustancias característicos de los organismos se llamasen orgánicas, las sustancias características del medio no-viviente se llamasen inorgánicas.
-
Dalton expuso su nueva versión de la teoría atómica basada en las leyes de las proporciones definidas y las proporciones múltiples.
-
Thoms Young fue el primero en entender la fisiología del ojo
-
Alessandro Volta halló que dos metales (separados por soluciones capaces de conducir una carga eléctrica) podían disponerse de modo que una nueva carga se crease tan pronto como la vieja se alejase a lo largo de un alambre conductor.
-
Proust demostró que el carbonato de cobre, contenía cobre, carbono y oxigeno en proporciones definidas en peso.
-
Nicols Vuquelin descubrió el berilio
-
Johan Gadolin descubrio un nuevo oxido metlico a la que se le dio el nombre de tierra rara
-
Lavoisier publicó un libro: Tratado elemental de Química que aportó al mundo una visión unificada del conocimiento químico en base a sus nuevas teorías y nomenclatura.
-
Klaproth alcanzó la fama después de haber descubierto algunos elementos: el uranio y el circonio.
-
Antoine Francois de Fourcroy elaboró un sistema lógico de nomenclatura.
-
Cavendish quemó una muestra de gas inflamable y estudió sus consecuencias, comprobando que los vapores producidos al arder se condensaban para formar un líquido que, al investigarlo, resultó
ser nada más y nada menos que agua. -
Peter Jacob Hjelm aisló molibdeno.
-
Lavoisier trató de determinar las proporciones relativas de carbono e hidrógeno en compuestos orgánicos quemándolos y pesando el dióxido de carbono y el agua que producían
-
Priestley dio lugar al descubrimiento mas importante, el mercurio, cuando se calienta en el aire,forma un calcinado de color rojo ladrillo.
-
Johann Gottlieb Gahn aisló el manganeso.
-
James Watts mejoró el ingenio de la máquina anterior y lo transformó en algo práctico.
-
Rutherford y Black estaban convencidos de la validez de la teoría del flogisto, trataron de explicar sus resultados en términos de dicha teoría: a medida que el ratón respiraba y las velas y el fósforo ardían, el flogisto se liberaba y se unía al aire, junto con el dióxido de carbono formado.
-
Lavoisier se unió a otros químicos para comprar un diamante que calentó en un recipiente cerrado hasta que desapareció.
-
George Stahl llamó flogisto al principio de la inflamable dado y después desarrollo un esquema que pudiera explicar la combustión basándose en el flogisto.
-
Lavoisier reconoció la importancia de las mediciones precisas. Así, su primer trabajo importante, trata sobre una investigación de la composición del yeso: lo calentó para extraer el agua que contenía, y midió luego la cantidad de agua liberada.
-
Joseph Priestley se hizo cargo de una parroquia en Leeds, Inglaterra, junto a la que, casualmente, había una cervecería. La fermentación del grano produce dióxido de carbono, que Priestley podía así obtener en abundancia para sus experimentos.
-
Joseph Black calentó fuertemente la piedra caliza, este carbonato se descompuso, liberando un gas y dejando cal tras de sí. El gas liberado pudo recombinarse con el óxido de calcio para formar de nuevo carbonato cálcico.
-
Axel Fredric Cronstedt descubrió un metal: el níquel
-
Cuando una sustancia contenía una cantidad de fluido eléctrico mayor que la normal, poseía uno de los dos tipos de carga; cuando contenía menos cantidad que la normal, poseía el otro tipo.
-
Charles Francois descubrió que habían dos tipos de carga eléctrica: una surgía en el vidrio y otra que podía crearse en el ámbar.
-
George Brandt estudio un mineral azulado que parecía mena de cobre, pero que, para desesperación de los mineros, no daba cobre cuando se sometía al tratamiento habitual. Los mineros pensaban que era un mineral embrujado por los espíritus de la tierra, a los que llamaban kobolds.
-
Thomas Savery constituyó una maquina de vapor a a alta presión que producía un vacío sin utilizar bomba de aire
-
Henning Brand fue el primero en descubrir un elemento desconocido antes del desarrollo de la ciencia moderna.
-
Johann Becher imaginó que los sólidos estaban compuestos por 3 tipos de "tierra"
-
Von Guericke demostró la presión ejercida por el peso de la atmosfera e invento una bomba de aire para extraerlo.
-
Evangelista Tortícolis probo que el aire ejercía presión e invento el barómetro.
-
Robert Boyle proyecto una bomba perfeccionada.halló que el volumen de una muestra de aire variaba con la presión según una proposición inversa simple.
-
William Gilbert fue capaz de demostrar que otras sustancias adquieren poder de atracción al frotarlas, se les conoce como eléctricas.
-
En el curso dela siglo XVII la Alquimia entró en decadencia y en el siglo XVIII se transformó en Química.
-
El libro de Agrícola "De Re Metallica", es el más importante trabajo sobre la tecnología química anterior a 1.700 y estableció la minerología como ciencia.
-
Con la publicacion de dos libros revolucionarios, por parte de Copérnico y Versalius, se derrocó la astronomía y la biología griegas.
-
Se dio debido a las cruzadas.Los escolásticos europeos asimilarán los hallazgos alquimistas del pasado e intentaron avanzar con ellos
-
Mantenimiento y extención de la alquimia en manos de árabes durante cinco siglos.
-
En Grecia, los filósofos se enfrentaron con la teoría química (los elementos)
-
En Grecia, Lucipo y su dicipulo Demócrito proponen esta teoria, pero no fue aceptada
-
Desarrollo de la quimica entre el 300 a. de C. Y 1.600 d. de C.
-
Bolos de Mendes fue su primer practicante reconocido. Se dedicó a la transmutación de los metales.
Looking for a timeline maker?
Create timelines for projects, roadmaps, history, lessons, legal cases, and stories with Timetoast. Timetoast is a timeline maker for work, school, research, and stories.